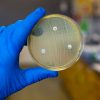

القاهرة 19 تشرين أول/أكتوبر2014 (د ب أ) – قامت وزارة الخارجية الألمانية بتعديل تحذيراتها بشأن الرحلات النيلية بين مدينتي الأقصر وأسوان / أبو سمبل، حيث باتت لا تمانع من القيام بها وبرحلات إلي المناطق والمواقع الأثرية في جنوب وادي النيل.
وقالت السفارة المصرية في برلين اليوم الاحد إن هذا التطور قد جاء بعد اتصالات مكثفة مع الجانب الألماني لتعديل التحذيرات التي سبق أن أصدرتها بقصر قيام السائحين الألمان برحلات في الجنوب بين القاهرة والأقصر فقط.
واشارت إلى أن هذه التعديلات تتواكب مع المؤتمر الدولي السنوي لاتحاد شركات السفر الألمانية QTA والذي عقد في الأقصر يومي 16 و17 تشرين أول/ أكتوبر 2014.
كما قامت وزارة الخارجية الألمانية بناء علي تدخل من السفارة المصرية بحذف التنويه الذي كانت قد وضعته علي صفحات عدة دول عربية وإسلامية وأفريقية، ومن بينها مصر، حول مخاطر اعتداءات تنظيم (داعش) في المنطقة وتهديد التنظيم باستهداف مصالح الدول الغربية، لما لها من مردود سلبي علي السياحة المصرية.